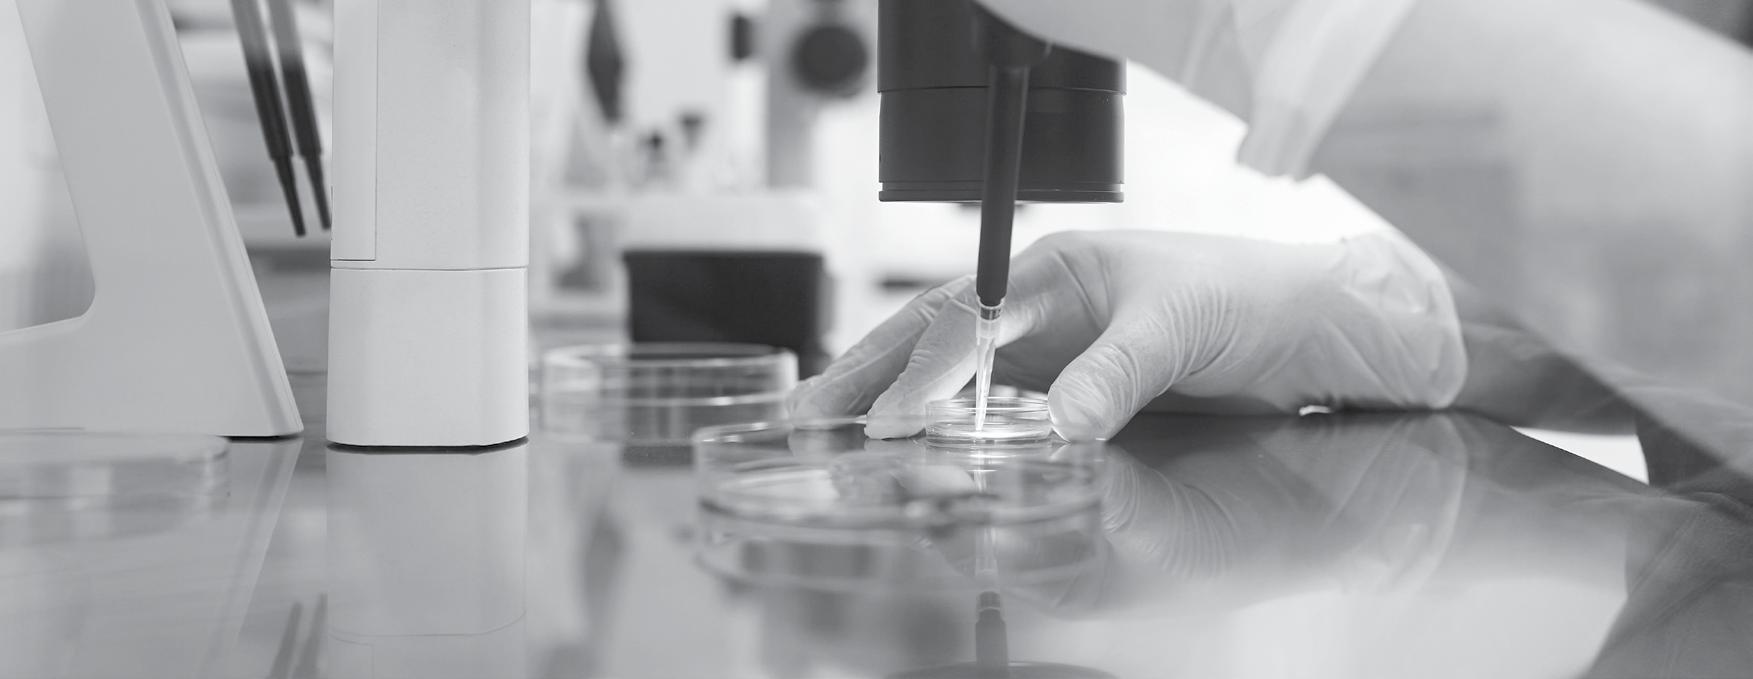

PRIVATE HEALTHCARE
An alternative to waiting

![]()

MARKETINGAND
Publishers of

The Healthcare media range of literature is distributed to 158 Health Districts throughout the UK. The Publications in the Healthcare media range are distributed free of charge to the general public through outlets comprising of Doctors Surgeries, Citizens Advice Bureaus, Nursing Homes, Registrars and Bereavement Services, Crematoriums, Children’s Centres, Maternity Units, Care Centres/Programmes, Hospices, Charities and NHS Clinics & Hospitals.
(Different titles are distributed to different outlets according to their readership profile - Not all titles are distributed by all outlets mentioned herewith).
The publications aim to provide invaluable advice to readers and are financed through the inclusion of relevant beneficial local advertising.
The range of publications
Bereavement Injury Advice
Making a Will and Funeral Planning
Older Persons Community Care
Mobility Advice
Private Healthcare Regaining Your Independence Relationship Breakdown Sight & Hearing
Work Related Injuries & Disease / Employment Issues
Pregnancy & Parenthood
Regional GP Appointment Cards
GP Antenatal Appointment Cards
Other products in the Impact range include


Please ask for a copy of the publications of your choice from your local range of outlets. If for any reason they do not hold stock of them please ask them to contact us or indeed feel free to contact us directly on the following links and request a copy of our publications via post or as a digital copy of any of the titles.



0115 944 7306 0115 944 0436 circulation@healthcaremedia.co.uk www.impactonlife.com

Impact Marketing & Publicity
Administration Office, Media House, 116-118 Derby Road, Stapleford, Nottingham NG9 7AD.

This guide is designed to offer an overview of private healthcare in the UK. People often are confused about how they can co-ordinate the services offered by the NHS and the private medical options to give them the best possible care and outcome. In the first part of the guide we outline the types of private services you can access and in the second part we offer you information about how to fund using these services. Infertility Treatment
Private Treatment for Addictions, Depression, Stress and Mental Illness Surgery in Private Hospitals
of
-
Fertility treatment funded by the NHS varies across the UK, and waiting lists can be very long in some areas. The National Institute for Health and Care Excellence (NICE) makes recommendations about fertility treatment and who should be eligible for NHS-funded IVF in England and Wales. However, these guidelines are not binding. In Wales, the Welsh Health Specialised Services Committee (WHSCC) makes the final decisions on eligibility for NHS-funded IVF, and their criteria may be stricter than those recommended by NICE. In England, eligibility is determined locally by Integrated Care Boards (ICBs), leading to variation between regions.
Make an appointment to see your doctor if you have not conceived after trying for a year, they will be able to advise about your eligibility for treatment.
If the NHS will fund your IVF in your local area or your GP will be able to refer you to a specialist, or contact your local Health Board.
If your GP refers you to a specialist for further tests, the NHS will pay for this. All patients have the right to be referred to a NHS clinic for an initial investigation.
If you have an infertility problem, you may want to consider private treatment. This can be a viable and easy option as you have no waiting times and many private clinics have some of the latest and most advanced fertility treatments although as with all clinics, there’s no guarantee of success. It’s important to choose a private clinic carefully.
Ask for a personalised, fully costed treatment plan that explains exactly what’s included, such as fees, scans and any necessary medication and also ask clinics for their live birth rate not just success rate.
If you decide to go private, you can ask your GP for advice. Make sure you choose a clinic licensed by the Human Fertilisation and Embryology Authority. The HFEA is a government organisation that regulates and inspects all UK clinics that provide fertility treatment, including the storage of eggs, sperm or embryos.
“
” Did you Know….. around 1 in 7 heterosexual couples may have difficulty conceiving.
“ ” Did
you know…. more than 8 out of 10 couples, where the woman is under 40, will conceive naturally within a year if they have regular unprotected sex (every 2 or 3 days).
IUI or artificial insemination is commonly used by people who are using donated sperm in their treatment, including single women and female couples, but can also be used by some heterosexual couples.
IVF is suitable for people with a wide range of fertility issues and is the one of the most commonly used and successful treatments available for many people.
It’s possible to have IVF with either less medication, or no medication at all. These treatments include natural IVF, mild stimulation IVF and in vitro maturation (IVM) and may be suitable for people who are unable to take fertility drugs due to an existing medical condition.
For around half of couples who are having problems conceiving the cause of infertility is spermrelated. ICSI is the most common and successful treatment for male infertility.
Some people with polycystic ovary syndrome or fertility problems caused by hormone imbalances may be able to have fertility drug treatment without needing to have a more invasive treatment like IVF or IUI.
If you have no, or extremely low numbers of sperm in your semen, you may be able to have sperm collected surgically.
Some conditions that affect your fertility may be treatable with surgery. This includes women with blocked fallopian tubes, endometriosis and fibroids and men who have had a vasectomy which they want to have reversed.
If you can’t use your own eggs and/ or sperm or you’re in a same sex couple or you’re a single woman, you’ll need to use donated eggs, sperm or embryos. Find out more about using sperm, eggs or embryos from a donor.
Surrogacy is the main treatment for same sex male couples who’d like to have a family. It can also be used by women who have a medical condition that makes it difficult or impossible to get pregnant and couples who have had repeated miscarriages or failed treatment cycles.
Local Health Boards (LHBs) are responsible for planning, delivering, and managing NHS services within specific geographical areas of Wales. These include primary, community, and secondary care, as well as services such as, dental care, eye care (optical, pharmacy services and mental health support.
They also work to improve physical and mental health, promote wellbeing in their communities, reduce health inequalities and Commission services from other organisations when needed.
NHS Trusts operate across the whole of Wales, providing specialist services or managing national functions such as public health, cancer and blood services and ambulance services.

When your GP decides you need to see a specialist, they will make a referral to the hospital or clinic. In most cases, your referral will go to services within your Local Health Board.
Unlike in England, there is no e-Referral system where you can choose and book your hospital online. Your Local Health Board will arrange your referral and let you know about your appointment.
The NHS aims for patients to start treatment within 26 weeks of the referral being received by the hospital. Some urgent referrals (for example, suspected cancer) are treated more quickly. Waiting times may be longer in some areas, depending on demand and capacity.
In most cases, you will be referred to hospitals or clinics within your Local Health Board. If the treatment you need is not available locally, your care may be arranged at a different hospital elsewhere in Wales, or sometimes in England.
Make sure the hospital has your correct contact details (phone number, address, email if possible). Let the hospital know as soon as possible if you cannot attend an appointment, so it can be given to another patient and a new date arranged for you. Keep in touch with your GP if your symptoms change or get worse while you are waiting. Ask your GP or hospital team for advice about managing your condition while you wait.
Patients often wonder whether private cancer treatment is better than the NHS. We’ve explained some of the differences below.
If you are treated for cancer via the NHS, you’ll be treated by a high quality, cancer specialist. Your assigned specialist will work with you to find the best and most suitable treatments. Treatment provided by the NHS is second to none – however increasing pressure and demand means waiting times are starting to become an increasing problem. Private health insurance can help provide that extra peace of mind – if you have the right cover or are able to self-fund you can often receive quicker access to scans and treatments.
Similarly to the NHS, once your cancer has been diagnosed you will be assigned a cancer consultant who will decide which treatments are going to be the most beneficial. However, it is more than likely that you will see the same consultant through your whole treatment process which can be reassuring and can also provide you with more time to discuss on-going symptoms.
According to the Macmillan Cancer Support Charity, the number of people living with cancer in the UK has increased from almost 3 million in 2020 to almost 3.5 million in 2025.
Each year around 400,000 people are diagnosed with cancer, in the UK. On average someone is diagnosed with cancer at least every 90 seconds, in the UK. The number of people diagnosed with cancer increased by 20% between 2009 and 2019 (reference ii). This is likely due to the growing and aging population who are at higher risk of developing cancer, as well as improvements in diagnosis initiatives and public awareness. Due to the disruption caused by the COVID-19 pandemic, cancer incidence in the UK decreased by 12% between 2019 and 2020, but increased again between 2020 and 2021.
Some cancer treatments at private hospital are not always available on the NHS as some private providers offer new treatments/procedures that the NHS does not offer.
Seeking treatment in a private hospital with cancer specialties can offer a wide range of new up to date and advanced diagnostic services such as tomotherapy, gamma camera, ultrasound, brachytherapy, gamma knife surgery in addition to MRI / CT scans. Your hospital will discuss the best options with you.
Treatments privately are available immediately with little or no waiting time and are carried out in the comfort of the private hospital.


Sometimes you may read stories about certain cancer drugs or treatments being available in some parts of the UK but not others. This has sometimes been called the postcode lottery. The National Institute for Health and Care Excellence (NICE) was set up to overcome this in England and Wales.
The All Wales Medical Strategy Group (AWMSG) looks at new medicines in Wales, especially before NICE has completed a review. The Scottish Medicines Consortium (SMC) advices for Scotland.
These organisations:
• Examine the scientific evidence for new treatments
• Assess how well they work
• Consider whether they are cost effective
• Decide whether they should be available on the NHS
take time — for example, if special equipment, facilities, or training are needed. It can be beneficial to go privately as a lot of private hospitals already offer services / treatments that some NHS trusts do not offer.
New treatments may be available privately even if they have not been fully tested in clinical trials. The NHS will not provide them because the evidence that the new treatment is better than the available standard treatments is not complete.
NICE cannot review them and recommend as a treatment until the clinical trials have been completed. Obviously if you read about new treatments in the press, you may find it hard to understand that the treatment is not available to you.
You may be able to get the treatment privately but you will have to pay and some cancer treatments can cost many thousands of pounds however your private medical insurance may cover this.
People seek private healthcare for a number of reasons, the most common being:
• a wish to avoid lengthy NHS waiting lists.
• concerns about hospital infections such as MRSA.
If NICE or AWMSG approves a treatment, health boards in Wales are expected to provide it. However, introducing new treatments can
• dissatisfaction about NHS treatment.
• wanting a second opinion.
The advantages over conventional NHS treatment are:
• Faster treatment access.
• A choice of when and where you can be treated.
• A choice of consultant.
There may be also access to treatment not available through the NHS.
In Wales, patients are normally referred to hospitals or clinics within their Local Health Board. Unlike in England, there is no national patient choice scheme. If the treatment you need is not available locally, your Health Board may arrange for you to have care at another hospital elsewhere in Wales, or sometimes in England.
Healthcare services in Wales are checked and regulated by Healthcare Inspectorate Wales (HIW) to make sure they are safe and meet national standards.
There are an increasing number of private patients units within NHS hospitals, which enable patients to be treated privately within the NHS environment. For many patients, this arrangement provides the reassurance of knowing that there is a full range of general and specialist medical services on site 24 hours a day.
Consultants who treat privately in NHS hospitals have generally 8
built up a specialist team, which is supported by on-site expert care, including specialist nurses and therapists.
The prices charged within NHS private units are highly competitive and, because they are recognised by all private health insurance companies, they can arrange for your account to be settled directly with them. When you are treated privately within an NHS hospital, it is usually possible to use private medical insurance (you should always check this with your insurance provider before agreeing to treatment) or to pay for yourself.
In addition, the income generated by the services provided to private patients within NHS hospitals goes back into the hospital’s general finances, benefitting patients across all areas of the hospital. For more information visit www.goprivate.com
Visiting a private GP as a patient is the choice of many people who need to fit in appointments at a time convenient to their busy lifestyles. Some private practices or clinics may offer additional facilities such as onsite pharmacy, X-ray, or scans.
It is expected by patients who choose private GPs that the doctor will have more time available for consultations and extended surgery hours.
Qualifications of private GPs should be the same as NHS doctors and they must be listed on the General Medical Council’s register.
Because private GPs and consultants are not as widespread as NHS doctors, you need to be aware that there might still be waiting lists for GPs and consultants. Do your research to make sure that going private will give you the service you are expecting.

It is possible to access private health care for certain treatments without going via a GP referral. For example:
Physiotherapy
Cosmetic surgery
Laser eye surgery
Health screening
Dentistry
Sport injury treatment
How do you find out the best service without a GP Referral?
You have various options to source a hospital, consultant or service.
• Referral from a friend or family member
• Information from a website comparing services
• Information for a particular private healthcare company via testimonials on their website
While you may be eager to find treatment for conditions that are limiting what you can do or reducing wellbeing, it is important that you research thoroughly, ask lots of questions and read with care any treatment plans offered you.
At present, private healthcare companies do not offer accident and emergency services and such treatment is not covered by health insurance. According to Private Healthcare Alliance some companies are looking at the potential for offering urgent but not emergency appointments in the London area because of the demand on the NHS services.
Apart from that, a full range of treatment is offered through private healthcare services. Examples include:
• Cancer care
• Orthopaedics including knee and hip replacements
• Weight loss surgery
• Fertility
• Cardiac care
• Gynaecology
• Psychology and psychiatry
• Nutritional counselling
Please note that in the case of cancer care, you need to check your private health insurance policies and the hospital’s own policies with regard to what is funded.
There is a wide range of treatment and care available in Wales for people seeking help with addiction, depression, or other mental health challenges. Because everyone’s situation is different, this guide cannot provide individual advice. However, the following website can help you explore the options that may suit your needs.
www.whatclinic.com www.rehabguide.co.uk www.addictionhelper.com www.goprivate.com
They will help you answer the questions you have. The questions might include:
• Do you need residential care, day treatment, or support at home?
• Is ongoing support available after the initial consultation or treatment?
• Do you need help with challenges beyond addiction or mental health, such as housing, finances, relationships, or legal issues?
• Do you need support for co-occurring issues, such as depression alongside addiction?
A wide range of major conditions can be treated via private hospitals including heart, spinal, thoracic as well as many life limiting conditions such as cataracts, and hernias.
Most surgeons in private practice also work in the NHS, there are strict rules on how these two commitments are balanced.
Surgeons entering private practice must be on the General Medical Council’s Specialist Register and have been accepted by the Advisory Appointments Committee (AAC), which is part of the NHS Consultant appointment process. Additionally, Healthcare Inspectorate Wales (HIW) regulates independent healthcare services in Wales, including some surgical practices.
By law, private hospitals have strict criteria for awarding practising privileges to doctors using their facilities. These ensure that patients receive treatment by experienced and fully trained registered specialists.
Two bodies in the UK oversee general surgeons: Association of Surgeons of Great Britain and Ireland and The Royal College of Surgeons of England.
“
” Did you know…. 1 in 4 people will experience a mental health problem of some kind each year in England.
While some cosmetic surgery procedures are available on the NHS in Wales, many are not considered essential medical treatments.
Exceptions include reconstructive surgery after accidents, cancer treatment, or severe psychological conditions.
These limitations have led to an increase in private facilities, where patients can access procedures such as breast augmentation or reduction, rhinoplasty (nose surgery), facial aesthetics, abdominoplasty, and male breast reduction.
Choosing a surgeon carefully is important. Consider their reputation and experience in the procedure you need. A GP referral can help you find a surgeon with experience in the specific procedure you are seeking. Only registered doctors can perform cosmetic surgery in Wales. To check if someone is a registered doctor or surgeon, consult the General Medical Council (GMC) online register.
Some surgeons hold a cosmetic surgery certificate from the Royal College of Surgeons (RCS), showing they meet agreed national standards. Some surgeons are also members of the British Association of Plastic, Reconstructive and Aesthetic Surgeons (BAPRAS).
All hospitals and clinics providing cosmetic surgery in Wales must be registered with Healthcare Inspectorate Wales (HIW), which regulates safety and quality standards.
Carefully review the terms and conditions of any cosmetic surgery finance package before committing.
While overseas cosmetic surgery packages may be cheaper, patients should carefully consider the risks and potential complications before proceeding.
An increasing number of people are opting for private dental care in the UK:
• For convenience
• For treatments not offered on the NHS such as restorative or cosmetic treatment (e.g., implants)
• For lack of NHS dentists in their area
• For treatment for phobias of dental work
The NHS has three charge bands depending upon the treatment needed. NHS dental treatments do not cover any cosmetic treatment. It is possible with a private dentist to schedule and finance non-urgent treatment such as restorative dentistry, which can improve the functionality and appearance of lost, damaged or decayed teeth. Private consultations allow patients to discuss personalised treatment plans for long-term oral health and aesthetics.
Cosmetic dentistry can restore confidence with treatments such as whitening or veneers. Orthodontic treatment can straighten adult as well as children’s teeth with a growing number of products such as Clearstep and Invisalign systems.
For those patients with private dental insurance such as Denplan, emergency treatment will usually be available.
All dentists providing cosmetic treatments in the UK must be registered with the General Dental Council (GDC).

Because of increasing costs, a growing number of people from the UK are choosing to go overseas for treatment, especially for cosmetic or orthodontic work. While it is possible to receive treatment at lower cost, it is advisable to research carefully into the qualifications of overseas practitioners and the regulation of such services.
Both NHS and private dentists in the UK are highly qualified, strictly regulated, and offer a wide range of treatments at varying costs.
Unfortunately, the mental health services in the NHS struggle to cope with the number of people needing treatment either as outpatients or in specialist inpatient units.
Some treatment, such as cognitive behaviour therapy, or child psychology though helpful to many people, are not available on the NHS or are subject to long waiting lists.
Private counsellors, psychologists and psychotherapists are available but iif you wish to begin treatment sooner, it is important to choose a practitioner who is properly qualified and registered with recognised professional bodies. British Association for Counselling and Psychotherapy and the UK Council for Psychotherapy are reliable sources of information. NHS Choices Services Directory is also a good source.
If you feel that psychiatric care might be appropriate for you, seek your GP’s advice in the first instance. Psychiatric care can cover a range of treatments for conditions such as OCD, depression, eating disorders, substance use, learning disabilities, personality disorders and bipolar disorder.
Some private companies may provide online services such as talking to a therapist over video chat or asking questions through a text messaging service. This maybe a benefit if you are finding it difficult to attend appointments in person.

Some patients may be entitled to free NHS sight tests (dependent on age, receipt of certain benefits, and potential conditions such as glaucoma), but most people will have to pay.
You can also choose to have an OCT (Optical Coherence Tomograph) scan as part of your eye examination, this may involve an additional fee even if your entitled to a free NHS eye test. OCT scans are sometimes offered privately for patients at risk of eye disease to provide detailed images of the retina, even if you are entitled to a free NHS eye test.
Eyesight tests are quite inexpensive and yet optometrists or ophthalmic opticians are highly trained, routinely screening patients for a number of possible health problems when undertaking tests. They are also able to correct a very wide range of eye conditions with spectacles or contact lenses.
Lightweight plastic lenses have largely done away with thick unsightly glass lenses, and frames now often carry the names of leading fashion designers.
Contact lens wearers, meanwhile, can now opt for soft lenses or disposable lenses for a very wide range of prescriptions. Lenses can even be bi-focal.
An alternative to wearing glasses and contact lenses is laser eye surgery, a painless procedure that takes only a very short time to perform. Although not suitable for everyone, laser eye surgery can correct common refractive errors such as myopia (short-sightedness), hyperopia (long-sightedness), and astigmatism, improving vision without glasses or contact lenses.
There are several different types of laser eye surgery and fees can vary, although generally the procedures are becoming less expensive as they become more popular.
In some circumstances, where staff use computer screens as part of their regular work, their employer will meet the cost of routine eye tests, although not the cost of spectacles or lenses.
Eye surgery, also known as ocular surgery, is surgery performed on the eye, typically by an ophthalmologist. Typical surgeries include:
• Cataract surgery
• Glaucoma surgery
• Refractive surgery
• Corneal transplant
• Vertoretinal surgery
• Eye muscle surgery
• Oculoplastic surgery
Why should I consider eye surgery in a Private Clinic/ Hospital if I can get it for free in an NHS fertility?
One of the benefits of choosing a private clinic/hospital over the NHS is due to the reduced waiting times. You can also choose the consultant to perform your eye surgery.
In many NHS facilities, the surgeon who makes your diagnosis may not perform your surgery, depending on operating schedules and staff availability.
Leading private eye clinics and hospitals often offer the latest advanced lenses, including premium intraocular lenses, which may not be available through the NHS. This enables the ophthalmologist to choose lenses best suited for your particular condition and/or needs.
Private clinics/Hospitals are equipped with the latest computerised and technologically advanced equipment. This is of importance when it comes to precise diagnosis, determining the best treatment and most suitable outcome for your particular eye condition.
Laser eye surgery is rarely offered on the NHS and is generally reserved for medical conditions that could cause sight loss. It is not provided for routine correction of refractive errors that can be treated with glasses or contact lenses.
“ ” Did you know….Nearly 3 in 5 (57%) people chose private healthcare so they could be seen more quickly.


With age, most people suffer from a degree of hearing loss. The NHS provides good quality digital hearing aids for free. Although the NHS usually provides behind-the-ear hearing aids, more discreet options such as open-fit or receiver-in-canal aids may also be available depending on clinical assessment.
Buying privately is an option, but we advise people to do their research and shop around. Ensure that any private dispenser is registered with the Health and Care Professions Council and that you do not feel pressurised into buying a particular make or model of hearing aid. Some audiology services in England are under the Any Qualified Provider scheme and further information about this can be found here www. nhs.uk
Royal National Institute for Deaf provides expert information on hearing aids. Visit www.rnid.org.uk
The skin is the human body’s largest organ and, as such, is subject to a vast range of conditions and diseases. 60% of people in the UK currently have a skin condition or previously had a skin condition.
Skin tags are very common and harmless. They are small flesh coloured or brown growths that hang off the skin and can occur anywhere on the body. They can vary in numbers and males and females are equally prone to developing them.
Although anyone can develop skin tags they can be associated with obesity. They can be popular in older people and people with diabetes and pregnant women can also become more likely to develop them due to the changes in hormone levels.
Generally, skin tags are harmless and do not require treatment. However, people consider getting them removed if they are of an unsightly appearance and affects your selfesteem. The removal of skin tags are usually done privately. The procedure is only usually done through the NHS if they are affecting your physical or mental health. Skin tags can be burnt or frozen off. They can also be surgically removed.
Moles are small coloured growths on the skin, usually brown or black, made up of cells called melanocytes. They can appear anywhere on the skin, alone or in groups. They can
be flat, raised, smooth or rough and some have hair growing from them. Also, moles can sometimes respond to hormonal changes such as pregnancy, teenage years and older age. Most moles appear in early childhood or during the first 30 years of a person’s life however, some can be present at birth. You are more likely to develop lots of moles, or a certain type of mole, if they are common in your family.
The vast majority of moles are not dangerous. However, they may be unsightly and therefore affect your confidence. These moles can be surgically treated although this can be expensive. You can also have a mole removed if it is a nuisance i.e., catching on clothing. If so, the surgeon may just shave the mole off so that it is level with your skin. This is known as a shave excision. The wound may then be closed with heat during a process called cauterisation.
Although most moles are benign, in rare cases they can develop into melanoma. Moles that are more likely to be cancer are those that look different than other existing moles or those that first appear after age 30. If you notice changes in a mole’s colour, height, size, or shape, you should have a dermatologist evaluate it. If moles become itchy, tender or painful or start to bleed, you should also have the moles checked.
The following ABCDEs are important characteristics to consider when examining moles. If a mole displays any of the signs listed below, have it checked immediately by a dermatologist. It could be cancerous.
• Asymmetry. One half of the mole does not match the other half.
• Border. The border or edges of the mole are ragged, blurred, or irregular.
• Colour. The colour of the mole is not the same throughout or has shades of tan, brown, black, blue, white or red.
• Diameter. The diameter of a mole is larger than the eraser of a pencil (around 6mm).
• Evolution. The mole is changing in size, shape, or colour.
The main treatment for melanoma is surgery. If this is diagnosed early then surgery is often successful.
Whether from an injury, surgery, or a skin problem such as acne, scars are something almost everyone has to deal with at some point. A scar is a mark left on the skin after a wound or an injury to the surface of the skin has healed.
The scar that you see on the surface of the skin is the result of a complex process the skin goes through as it recovers from damage. When the skin is wounded and there is a break in the body’s tissues, it produces a protein called collagen. This builds up where the tissue has been damaged to help heal and strengthen the wound.
For around 3 months, new collagen continues to form and blood supply increases, causing the scar to become raised, lumpy and red. Some collagen then breaks down at the site of the wound, the blood supply reduces and the scar gradually becomes smoother, softer and paler.
Whilst scars are permanent, they can fade for up to two years. Usually after this point it is unlikely they will fade anymore. There are a variety of different treatments for scars which may help to improve their appearance.
Although they are unlikely to disappear completely, most will fade over time. For unsightly or uncomfortable scars, treatment options include:
• Silicone gel sheets
• Pressure dressings
• Corticosteroid injections
• Cosmetic camouflage (make-up)
• Surgery
A combination of treatments can usually be used.
Varicose veins are gnarled, enlarged veins, usually blue or dark. Any vein may become varicose, but the veins most commonly affected are those in your legs and feet as standing and walking puts extra pressure on the veins in the lower body. They may also be lumpy, bulging or twisted in appearance. For many people, varicose veins are simply a cosmetic concern. For others, they can cause aching pain and discomfort.
Varicose veins develop when the small valves inside the veins stop working properly. The blood is prevented from flowing backwards by a series of tiny valves that open and close to let blood through.
If the valves weaken or are damaged, the blood can flow backwards and collect in the vein, eventually causing it to be swollen and enlarged (varicose).
Pregnancy, being overweight and old age can increase your chances of developing varicose veins. Generally, varicose veins don’t present a serious health problem so usually doesn’t require treatment.
If treatment is necessary, your doctor may recommend up to six months of using compression stockings, taking regular exercise and elevating the affected area when resting. If they are still causing discomfort, they may be treated by:
• Endothermal ablation
• Radiofrequency ablation
• Endovenous laser therapy
• Sclerotherapy
If these two treatments are unsuitable for you then you are usually offered a surgical procedure called ligation and stripping to remove the affected veins. There are numerous medically qualified lead skin clinics worth trying for treatments to any skin issues.
Alopecia is a generic medical term for all forms of hair loss, from patchy baldness to diffuse thinning or total loss. Although alopecia is not life threatening and is rarely accompanied by physical pain, the attached emotional and psychological suffering is often very high, affecting careers, marriages and self-esteem.
Treatment and support for alopecia is available through the NHS. A number of private clinics and practitioners also offer treatments including complementary therapies and aromatherapy treatments. Information is widely available on the Internet and you may wish to contact an organisation such as Alopecia UK or Alopecia Awareness (www.alopecia.org.uk).
In 2022 to 2023 it is estimated that a third of adult in Wales are living with obesity. In Wales, most people can manage their weight through healthy eating, regular exercise and, if needed, medication. Weight-loss surgery (also called bariatric surgery) is only offered on the NHS as a last resort for people living with severe, long-term obesity.
To be considered for NHS surgery in Wales, you must fulfil certain criteria and surgery will only go ahead if it’s part of a wider care plan. This means you’ll continue to get support with diet, lifestyle changes and follow-up appointments after your operation.
Some people choose to look at private options, such as gastric balloons, gastric bands or gastric bypasses. If you’re thinking about this, it’s really important to talk things through with your GP or consultant first. Surgery always comes with risks, and you’ll also need to make sure you have a clear plan for aftercare. While the NHS can provide urgent treatment if something goes wrong, it doesn’t usually cover routine checkups after private surgery.

Women are choosing private medical care for a wide range of problems that are not life threatening but can prove chronic, for reasons of convenience and speed in receiving treatment.
These include varicose veins, breast screening, a variety of menstrual problems, alopecia, osteoporosis and incontinence. They may also prefer a private clinic in matters of unwanted pregnancy, sexual infections, contraception or sterilisation.
There are a number of centres around the UK that offer private services specific to women’s health. This allows women the chance to be seen at times more convenient to them in their busy lives.
Pregnant women are usually offered two (or occasionally three) ultrasound scans on the NHS to check the growth and development of their baby. A growing number of expectant parents want to see their developing baby more regularly during pregnancy, usually for reassurance or perhaps because they have concerns about a specific issue. A number of private clinics and organisations offer private baby scans.
A 3D/4D scan shows the baby in three dimensions and moving in real time. These scans can be a magical way of enabling parents to see their child’s face before it is even born. 3D/4D scans offered through private companies usually include a range of
package options including photographs and DVD copies of the scan. These ‘bonding’ scans are not usually carried out for medical purposes however.
Many male health conditions develop gradually and are easy to ignore in the busy everyday life.
A number of private clinics in the UK now specialise in men’s health procedures offering a professional and caring environment where tests can be carried out. Conditions commonly addresses include prostate problems, testicular cancer, vasectomy or reversals, fertility, hernias, impotence or circumcision.
There are also private sexual health clinics specialising in male problems including erectile dysfunction and sexually transmitted diseases.
While GP referrals are possible, many private clinics accept selfreferral, which some patients prefer to avoid potential embarrassment at local NHS services.
Physiotherapy can be highly effective in the treatment of a wide range of issues and injuries, including back pain, sports injuries and arthritis.
A physiotherapist will use a combination of manipulation, exercise and massage techniques to help rehabilitation. Physiotherapists are trained practitioners and are
regulated by two main bodies in the UK. If you choose to visit a private physiotherapist, you should check that they are registered with the Health and Care Professionals Council (HCPC).
Most physiotherapists will also be registered with the Chartered Society of Physiotherapists and members must hold Professional Indemnity Insurance.
It is possible to access physiotherapy through the NHS, private sector or independent sector. Direct or self-referrals are also becoming increasingly popular, especially for people who need physiotherapy to help with the management of a long-term condition as self-referral usually means shorter waiting times for patients.
Your GP can give you details of local physiotherapists or your employer may run an occupational health scheme that includes physiotherapy treatment, in which case you should check with your human resources department to see if you are eligible.
If you decide to visit a private physiotherapist, you will be expected to pay for any treatment you receive. You can find a directory of private physiotherapists at www.physiofirst.org.uk and can search for practitioners based upon the expertise you require e.g., for help with pain management, treat a sports injury or related to women’s health, including problems during and after pregnancy.
Make sure that you feel comfortable with your chosen physiotherapist (you should be able to request a male or female therapist if this matters to you) and that they explain your treatment in advance, as well as the anticipated length and cost of the treatment plan.
Podiatrists (also known as chiropodists) are foot specialists who diagnose and treat diseases and abnormalities of the lower limb. They can provide professional advice on existing foot problems and give proper foot care advice for people of all ages, including infants and older people.
A podiatrist will often see people who are at high risk of foot problems or even amputation, due to illnesses such as diabetes. They can also help monitor and manage problems and

Foot problems are very common and can be a significant cause of pain and disability, which in turn can lead to issues such as social isolation and loss of independence, particularly in older patients. Podiatry services are available on the NHS but with an ageing population, may be limited in some areas to higher risk patients or in great demand.
You can ask for a referral through your GP or go straight to a private podiatrist for treatment.
The British Chiropody and Podiatry Association is the largest professional body representing independent private chiropodists and podiatrists in the UK. State regulated podiatrists are represented by The College of Podiatry.
Osteopathy emphasises the role of the musculoskeletal system in health and disease. Osteopaths take a holistic approach and are trained to work with the structure and function of the whole body, based on the understanding that its wellbeing depends on the muscles, ligaments and connective tissues functioning smoothly together.
Osteopaths have extensive training and are recognised as primary care physicians. They focus on preventative medicine and caring for the musculoskeletal system to reduce problems.
In their effort to reduce bodily aches and pains, they may also seek to treat functional disorders related to the respiratory or digestive systems, for example.
Osteopaths typically treat back and neck pain, repetitive strain injury, changes in posture and resulting problems during pregnancy, postural problems caused by driving or work strain, arthritis and sports injuries.
Some osteopaths specialise in visceral osteopathy (organ function and movement) or cranial osteopathy, which focuses on the movement of cerebrospinal fluid. In fact, cranial osteopathy is often an effective treatment for headaches, migraines and sinus problems; stress; recurrent infection; period pain; and digestive difficulties. In babies and young children it may also relieve colic, crying and feeding difficulties.
Osteopaths usually use a number of techniques to employ the body’s innate healing system; these usually use subtle, gentle movements and
include soft tissue and muscle work, joint articulation and mobilisation / manipulation. All osteopaths working in the UK must be registered with the General Osteopathic Council.
As osteopathy is classed as a complementary treatment, its availability on the NHS varies around the country and, where it is available, appointments may be limited. You should speak to your GP or Integrated Care Boards (ICB’s) to see whether you can be referred to an osteopath through the NHS. Most people pay to receive osteopathic treatment on a private basis.
Chiropractic is a healthcare discipline similar to Osteopathy and is now recognised by the medical profession. Chiropractors are concerned with the framework of bones and muscles that support the body – this is known as the ‘musculoskeletal system’ – and the effects that disorders of the musculoskeletal system can have on the function of the nervous system and a patient’s general health.
Some problems of the musculoskeletal system are due to everyday wear and tear, but they can also be caused by accidents, stress, illness, poor posture, lack of exercise, or even pregnancy.
Symptoms typically treated by a chiropractor include upper, mid or lower back pain; neck pain and stiffness; shoulder pain; numbness or tingling; pain in the extremities (arms and legs); hip pain; knee pain; ankle or foot pain; headaches; or jaw pain.
When you see a chiropractor, they may manipulate parts of your spine or joints to address the pain or discomfort you are experiencing. Manipulation involves precisely handling or moving joints or parts of the spine, sometimes moving them further than their normal range of movement – it is very common to hear a clicking or popping noise as your joint is being manipulated and nothing at all to worry about.
When you first see a chiropractor, they will take a full case history and will ask your permission to carry out a thorough physical examination. They may take or send you for X-rays if they are needed. A chiropractor will probably also give you advice about exercise, self-help, diet and lifestyle to help treat the problem.
In the UK, chiropractors are required by law to register with the General Chiropractic Council.

The terms ‘complementary therapies’ or ‘complementary medicine’ cover a very wide range of methods of treating people for ailments of one kind or another. Conventional medical circles now recognise certain complementary therapies and, in recent years, there has been a significant positive shift in attitude towards such treatments in general.
Here we highlight several of the more popular therapies, some of which are now fully accredited.
Many private medical insurance policies now include some complementary therapies. If you are intending to claim it is important that you check which ones are included before you begin a course of treatment with a therapist. It is also important to check with the therapist the arrangements they have for dealing with medical insurance companies.
With regard to registered qualifications for complementary therapies, they can vary between different therapies. It is important therefore to check:
• The therapist’s experience, qualifications and professional insurance status
• The medical insurance company’s criteria before they will pay out.
The Health and Care Professions Council covers professions such as podiatrists and physiotherapists but there is no one body that covers all complementary therapies.
ACUPUNCTURE is an ancient therapy of Chinese origin in which needles are inserted into the body at certain key points. Two somewhat different forms are available today, one firmly rooted in the ancient Chinese tradition and one based on Western medical thinking. The latter is practised by some GPs and hospital doctors to complement the more conventional treatments that are generally available. They may use it for pain relief or to treat a range of conditions, including some allergies. Followers of the Chinese method, however, say that the treatments they give can be used to deal with a wider range of ailments.
ALEXANDER TECHNIQUE is a means of improving poor posture which otherwise can result in back, shoulder and neck pain, together with other problems. It helps to ensure the body is properly aligned, thus removing stress and tension. The technique is based, in part, on self-help in that people are taught how to overcome problems of posture that can lead to health problems as the energy enters their body.
AROMATHERAPY uses essential oils from various aromatic plants and flowers to enhance health and wellbeing. The oils are usually applied by massage, although they can also be used in baths for relaxation or applied to the body on a compress.
CRANIOSACRAL THERAPY is a very gentle therapy that can be used with anyone from babies to elderly people. In treatments, the therapist applies their hands very lightly to the patient’s fully clothed body, detecting and relieving pain or tension. Craniosacral therapists work with people who have a very wide range of conditions including,
among others, asthma, bronchitis, depression, insomnia, rheumatism and migraine.
HOMEOPATHY involves treating people holistically; that is to say treating the person as a whole and not just the ailment from which they are suffering. It also encourages the body to heal itself. Different homeopathic remedies may be given by the same practitioner to different people presenting with the same ailment, because it may be perceived that the causes of their ailment may be different.
HYPNOTHERAPY is based on placing people into a state of hypnosis and then applying various psychological techniques to help them with their particular problems.
It is used to help people with addictions such as smoking, to help overcome anxiety, nervousness and stress, among other things
NEURO-LINGUISTIC PROGRAMMING
(NLP) is now a well-known way of helping people access successful strategies to eliminate negative habits and improve their lives. Used with or without hypnosis, it is proving increasingly popular in coaching and health circles, and focuses on how people think, behave and change.
You may find the two sites listed below useful if you wish to investigate how these strategies may improve your health and find a reputable practitioner:
www.anlp.org www.chisuk.org.uk
REFLEXOLOGY practitioners apply pressure to key points on a patient’s feet, or sometimes their hands. This is based on the principle that all organs in the body are reflected on the hand or foot.
As with many other therapies, reflexology works holistically, treating the whole person and not just the symptoms they are presenting. The therapy works on the basis that illness or injury may have caused a person’s energy pathways to be blocked. Practitioners identify the blockages and release them, allowing energy to flow around the body again and help it to heal itself.
REIKI is derived from ancient natural healing beliefs and principles. Patients are fully clothed and practitioners place their hands very close to or lightly touching key parts of the body. They then channel energy through themselves via their hands to the patient who may experience warmth as the energy enters their body.
REMEDIAL MASSAGE is mainly used to treat painful problems with muscles, tendons and joints. Practitioners establish with each individual client how the pain began so that they can trace the actual cause. This then enables them to address the problem in the most appropriate way. Among the wide range of conditions for which remedial massage is used are muscle spasms, pain resulting from scar tissue, joint pain, muscle ache and repetitive strain injury.
SHIATSU is a Japanese therapy that encourages relaxation and helps people to reduce their stress levels. It is based on the principle that vital energy (or ‘ki’) flows through the body. If this energy flow is stopped then health problems can result. Practitioners manipulate various parts of the body to encourage the energy flow. In doing so, they treat a number of conditions including painful joints, backache, sports injuries, headaches, migraine and depression.
Funding for care is available through your local authority, but pressure on local and central government budgets can sometimes limit the options available. Typically, funding will cover a certain standard of care, but if you or your family choose a more expensive option, you may need to pay the difference. This is called a ‘third-party top-up payment’.
Before deciding to pay for care yourself, it is important to have a local authority assessment. This ensures that if you are later unable to continue paying your own fees, you will still be eligible for publicly funded care without problems.

Rules around care fees—whether in a care home or receiving care at home—can be complex. Organisations such as Age Cymru and the Elderly Accommodation Counsel offer advice and information specific to Wales and can help you understand your options.
You can order a copy of our free ‘Older Person’s Community Care Guide’ about the NHS and private services and funding available to older people. This guide gives you more information about living independently in your own home as well as your options when choosing and paying for a care home.
If you are worried about having an accident or falling ill while you are in your own home alone, community alarms provide emergency access that is staffed 24 hours a day, 365 days a year. The community alarm is connected to your telephone line and can be activated via a pendant worn around the neck or a wrist band. They provide reassurance to your family and friends that help, if needed, is only a touch of a button away.
Telecare systems are a range of simple sensors that either raise an alarm or act as a reminder to help to keep you safe and independent in your own home, they include items such as: door sensors, movement sensors, medication reminders and smoke, gas or flood detectors.
The housing department of your local council, Age UK and private companies provide this valuable service.
Bereavement is one of the most distressing experiences we face as human beings, and often comes hand in hand with unexpected financial pressure. A pre-paid funeral lets you plan all your funeral arrangements in advance and ensure that the funds are in place to pay for them. This can save your loved ones unnecessary stress and worry in the future.
There are a number of pre-paid funeral plans available. To make sure you choose the right plan, think about what it includes, which services are guaranteed (and which aren’t),
whether you can add your personal wishes, or even pay for extra details that you might want to include.
Since July 2022, the Financial Conduct Authority has been regulating firms that provide and arrange prepaid funeral plans. This means that your money is safe with an authorised provider, you are protected by the Financial Services Compensation Scheme should your plan provider fail and if you have a complaint against a funeral plan provider or intermediary you can refer it to the Financial Ombudsman Service.
People seek private health care for a number of reasons, the most common being:
• A wish to avoid lengthy NHS waiting lists
• Easier to book private healthcare appointments
• Get a more personalised care
• Faster access, more choice, and greater comfort.
The advantages over conventional NHS treatment are:
• Faster treatment access
• A choice of when and where you can be treated
• A choice of consultant
• Work provided healthcare package
• Self pay
• Hospital cash plans
• Medical loans
Critical illness insurance (particularly appropriate for self-employed people)
• Income protection insurance
• Life insurance
• Personal accident insurance
• Health cash schemes
• Finance schemes
• Dental insurance www.which.co.uk offers reports on different kinds of health insurance.
Some employers in Wales offer private healthcare cover as part of their staff benefits. This kind of cover can make it easier to arrange medical treatment at a convenient time and may help you get back to work more quickly if you’ve been unwell.
There may be also access to treatments not available through the NHS.
Not every job includes this benefit, so it’s best to check your contract of employment or ask your Human Resources (HR) department if you’re unsure.

As with buying any type of insurance such as home or buildings, before you choose a policy, it is sensible to sit down and decide what you need such a policy to do for you and/or your family. You might like to take into account any of the following:
• Pre-existing conditions (many policies exclude incurable illnesses or substance dependency).
• What essential treatments you might need such as consultations, surgery, nursing and hospital care
• Any additional treatments you might consider such as complementary therapy
• Any additional requirements such as personal accident cover.
Policies are generally divided into two types:
Fully underwritten: the company requires full disclosure of all your medical history and can then decide what they will cover or exclude.
Moratorium: a full disclosure is not required but the company can impose wide-ranging exclusions that go back a set number of years.
Specialist: Some insurers offer specialist policies, which may cover only certain conditions, focus on specific age groups (e.g., over 55s), or provide coverage for treatments after a specified waiting period.
Check also if your provider (e.g., hospital) is covered by your insurance.
Private medical insurance does not cover accident and emergency (A&E) treatment and cannot guarantee faster access for life-threatening or urgent conditions.
Other types of insurances are:
• Cancer-only medical insurance
• Critical illness cover
• Life and critical illness cover
• Stand-alone critical illness
• insurance
• Income protection insurance
• Personal accident insurance
• Life insurance
• Travel health insurance
• Fixed-price surgery schemes
• Healthcare cash plans
• Cosmetic surgery insurance
• Dental insurance

Since modern healthcare emphasises both the prevention and treatment of health problems a health assessment can provide early warning of potential problems. Fixed price health assessments are offered by a number of private companies.
They typically include a medical history and lifestyle questionnaire; a physical examination; a consultation with a doctor, trained health adviser or nurse, which gives you the time to ask questions.
Many test results are available on the same day, along with a personalised health report and an action plan to help you reduce future health risks.
Some cosmetic dentistry, nonsurgical facial aesthetic procedures such as chemical peels, Botox or dermal fillers are covered by some private healthcare organisations. Cover can also be offered for self-referral to physiotherapists or osteopaths. Even seasonal flu vaccinations can be bought and administered through pharmacies such as Lloyds Pharmacy.
you

You need to feel comfortable with your provider, whether that is a GP, dentist, hospital or surgeon. Any provider should offer you adequate information about their services, taking into account your needs.
Always check that the hospital you choose follows an external complaints code, adjudicated by an external body, qualified to assess its procedures and services.
All hospitals, primary dental care, healthcare and social care, and GPs in Wales are inspected and monitored by the Healthcare Inspectorate Wales (HIW) and their reports can be found at www.hiw. org.uk. Both NHS and independently funded or voluntary organisations are covered.
As regards buying private health insurance, there are ways to ensure that you pay for only what you need. It makes sense as with buying any service to ask for and examine thoroughly several quotations.
While health is an emotive issue for us, when you purchase insurance, you are entering into a contract with the provider of the insurance and you need to think carefully about what you are buying
• Choose and pay for only the cover you need – a single person may not need cover for family, children or pregnancy. You may choose to limit cover to certain major illnesses.
• Share the risk – some shared risk policies have high excesses, while others mean your insurer covers 30-75% of the costs and you cover the rest.
• Choose the level of excess. Moving from £100 to £1000 can substantially affect your monthly premiums
• Choose your waiting period – for example, accept treatment on the NHS within six weeks then choose immediate treatment after that time.
• Build up no claims and low claims discounts on your policy. As with car insurance, discounts are available over a period of 8 years of no claiming.
• Restrict your choice of hospital provider. Some insurers offer restricted lists of hospitals, i.e., those they have negotiated discounts with and you benefit with reduced premiums. The wider your choice, as is possible, the higher your premiums
• Buy online – you can save up to 10% for buying online.
• Pay annually and receive discounts.
• Stay healthy – premiums are increased for people who are obese or who smoke, and reduced for those with a healthy lifestyle.
Before you agree with a provider, make sure you receive a personalised treatment plan that itemises the costs and exactly what it includes.
If you have used an independent health practitioner and wish to make a complaint about your experience or the treatment you have received, you are advised to firstly contact the medical profession in question and go through their official complaints procedure. If you are unhappy with the response of your complaint then you may be able to contact the Independent Sector Complaints Adjudication Service (ISCAS). ISCAS represent some independent healthcare providers, who must adhere to the ISCAS’s complaints code. The ISCAS publish a guide for patients who wish to make a complaint in the Independent Healthcare Sector on their website.

Listed below are a number of organisations that will be able to give you more advice about meeting your requirements. This is by no means an exhaustive list and you may find that there are local organisations who can tell you more about the services on offer in your area.
If you are living in England or Scotland, you are advised to read our English or Scottish edition of the Private Healthcare guide as many of the organisations listed below have a dedicated England or Scotland branch, and different rules, regulations and legislation may apply.
Addiction helper are an online addiction support for people with addictions and family of people with addictions such as alcohol, drugs and other addictions such as eating disorders, gambling and shopping.
Helpline 0808 304 6108
www.addictionhelper.com

Age Cymru, Ground Floor, Mariners House, Trident Court, Cardiff, CF24 5TD
Advice Line : 0300 303 44 98

Mon-Fri 9am - 4pm
All other enquiries: 029 2043 1555
Email: enquiries@agrcymru.org.uk www.ageuk.org.uk /cymru
Association of British Insurers
For information about private medical insurance
British Academy of Cosmetic Dentistry
85 Great Portland Street, London W1W 7LT
British Association of Aesthetic Plastic Surgeons
38-43 Lincoln’s Inn Fields, London, WC2A 3PE
For information about cosmetic surgery
British Association for Counselling & Psychotherapy
BACP House, 15 St John’s Business Park, Lutterworth, Leicestershire, LE17 4HB
General Enquiries: 020 7600 3333
Email: info@abi.org.uk www.abi.org.uk

Email via the online contact form www.bacd.com
Tel: 020 7430 1840
Emai: info@baaps.org.uk www.baaps.org.uk

General Enquiries 01455 883300 Mon - Fri 10am - 4pm
Email: bacp@bacp.co.uk www.bacp.co.uk
British Chiropody & Podiatry Association
New Hall, 149 Bath Road, Maidenhead Berks SL6 4LA
Tel: 01628 621100
Email via online contact form www.bcha-uk.org
British Health Care Association
Unit 8 Cherry Hall Road, North Kettering Business Park, Kettering, NN14 1UE
BHCA represents most of the UK’s health cash plan providers
Tel: 01536 519960
Email: rosa.mcalindon@bhcaservices. co.uk www.bhca.org.uk
British Register of Complementary Practitioners (BRCP)
PO Box 101 Somerton TA11 9BY
Provide support and services for complementary therapy practitioners.
Cancer Care Map is an online resource to help people living with cancer find care and support services in their local area, anywhere in the UK.
Tel: 0300 302 0715
Email via the online contact form www.brcp.uk
www.cancercaremap.org
Welsh Government Office, Sarn Mynach, Llandudno Junction LL31 9RZ
We register, inspect and take action to improve the quality and safety of services for the well-being of older people in Wales.
Tel: 0300 7900 126
Email: ciw@gov.wales www.careinspectorate.wales
The Chartered Society of Physiotherapy
The Chartered Society of Physiotherapy (CS) is the professional, educational and trade union body for the UK 65,000 chartered physiotherapist, physiotherapy students and support workers.
Tel: 029 2038 2428

Email: wales@csp.org.uk www.csp.org.uk X @thecsp
Dan 24/7
Wales Drug and Alcohol Helpline.
Freephone: 0808 808 2234 or text Dan to 81068
Email: dan@helpline.wales www.dan247.org.uk
Denplan
Anton House, Chantry Street, Andover, SP10 1DE
www.denplan.co.uk
Help older people make informed choices about meeting their housing and care needs.
www.eac.org.uk

Park House, 186 Kennington Park Road, London SE11 4BT
Regulators of chiropractors in the UK to ensure the safety of patients undergoing chiropractic treatment.
Tel: 020 7713 5155

Email: enquiries@gcc-uk.org www.gcc-uk.org
General Dental Council
Independent organiastion which regulate dentist and dental care professionals in the UK.
Customer Service Team 020 7167 6000 Mon - Fri 9am - 5pm
Email via the online contact form www.gdc-uk.org Facebook/X
General Medical Council
Protect patient safety and improve medical education and practice across the UK.
Tel: 0161 923 6602 Mon - Fri 9am - 5pm Message Chat SMS 07723571541
Email: gmc@gmc-uk.org www.gmc-uk.org

The General Osteopathic Council regulates osteopaths in the UK.
To find an osteopath in your area or to confirm if an osteopath is registered with us you can search our Register on our website, which is updated daily.
Tel: 020 7357 6655

Email: info@osteopathy.org.uk www.osteopathy.org.uk
Go Private (previously known as Private Healthcare UK)
The UK’s biggest online resource for patients seeking information about the private healthcare sector.
www.goprivate.com
Health & Care Professions Council
184 -186 Kennington Park Road, London, SE11 4BU.
Regulators of health and care professionals in the UK.
Switchboard: 0300 500 6184
www.hpc-uk.org
To send us an email, check our website as email address vary according to the nature of your enquiry.
Independent inspector and regulator of NHS healthcare and independent healthcare organisations in Wales.
Lettsome House, 11 Chandos Street London, W1G 9EB
Second Floor, Thomas House, 84 Eccleston Square, London. SW1V 1PY
Representative body for the Independent sector of healthcare providers
Tel: 0300 062 8163
Email: hiw@gov.wales www.hiw.org.uk
Tel: 020 3696 4080
Email via online contact form www.idf.co.uk
Tel: 020 3948 1332
Email via the online contact form www.ihpn.org.uk
23 St Leonards Road, Bexhill on Sea, East Sussex TN40 1HH
Provides free and impartial support, advise, information and understanding for anyone affected by fertility issues.
Support and Information Line 01424 732361
Email: support@fertilitynetworkuk.org www.fertilitynetworkuk.org Facebook/X
At Switchboard we provide information, support and referral service for lesbians, gay men and bisexual and trans people – and anyone considering issues around their sexuality and/or gender identity.
Tel: 0800 0199 1000 Open 10am – 10pm every day
Email: hello@switchboard.lgbt www.switchboard.lgbt
National Obesity Surgery Centre
For more information visit www.obesitysurgerycente.com
NHS Wales Call 111 (if you need medical help fast but it’s not a 999 emergency)
www.111.wales.nhs.uk
Smile House, 2 East Union Street, Rugby, Warwickshire CV22 6AJ
Tel: 01788 546 365 (local rate call in UK)

Email: mail@dentalhealth.org www.dentalhealth.org
The Patients Association, PO Box 935, c/o Aspire Business Partners, 32 Byron Hill Road, Harrow, HA1 3YJ.
The Patients Association exists to represent every patient in the UK.
Helpline 0800 345 7115 Weekdays 9.30am - 5pm
Email via the online contact form www.patients-assocation.org.uk
Physio First
Victory House, 400 Pavilion Drive, Northampton Business Park, Northampton NN4 7PA.
Tel: 01604 684960 Mon – Thur 9am – 5pm Fri 9am – 4.30 pm
Email: info@physiofirst.org.uk www.physiofirst.org.uk
The Private Healthcare Information Network
The independent, government-mandated organisation publishing performance and fees information about private consultants and hospitals.
General Enquiries 0203 4 79 3810
Email: info@phin.org.uk www.phin.org.uk
The Royal National Institute of Blind People, is the UK’s leading sight loss charity. We offer practical and emotional support to blind and partially sighted people, their families and carers.
Helpline 0303 123 9999

Email via the online contact form www.rnib.org.uk Facebook/X
Advice and support for people who are deaf, hard of hearing or have tinnitus. We want a world where hearing loss doesn’t limit or label people, where tinnitus is silenced - and where people value and look after their hearing.
Information Line 0808 808 0123

Text your question to 07360 268 988
Relay UK 18001 0808 808 0123
Email: contact@rnid.org.uk www.rnid.org.uk Facebook/X
PO Box 55, Alfreton, Derbyshire, DE55 4RF
Find a group near you using the group enquiries number.
Head Office 0344 892 0400
Group Enquiries: 0344 897 8000

Email via the online contact form www.slimmingworld.com
The College of Podiatry, Quartz House, 207 Providence Square, Mill Street, London SE1 2EW
Email: contact@rcpod.org.uk
www.cop.org.uk

The information provided in this publication is given in good faith and is in no way connected to or affiliated with any of the organisations contained within this publication. The information supplied should not be taken as legal advice.
The content is also not intended to replace other healthcare professional advice that you may be encouraged to seek.
Professional advice should be sought where appropriate. Any rates and information contained within this publication was correct at the time of writing in November 2025.
As benefit entitlements change regularly, you are advised to contact the benefits enquiry line or your local jobcentre plus for information about current entitlements.




This booklet gives you a helpful overview of private healthcare and explains how to coordinate NHS services with private medical options, so you can get the best possible care and outcome. You can also scan the QR code to visit our website, where you’ll find our extensive list of helpful publications.










